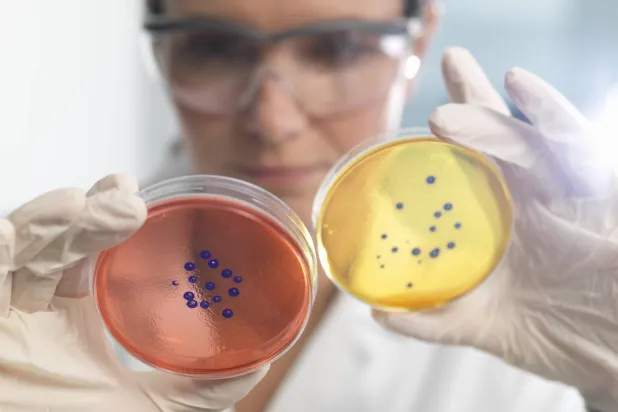
«مقاومة المضادات الحيوية»... خطر صامت يهدد المرضى

- جريدة الشعب: العدد 13373 بتاريخ 20-11-2025
- توقيع اتفاقية الحج لموسم 1447 بين بلادنا والمملكة العربية السعودية
- سفارة بريطانيا بنواكشوط تحتفي بذكرى ميلاد تشارلز الثالث
- الحزب الحاكم يدعو لهبة شعبية لترسيخ المفاهيم التى دعا لها غزواني
- الحكومة: المساعي المُهوّنة لجهودنا في التعاطي مع المهاجرين تعُوزها الوطنية
- نقابة أساتذة التعليم الفني تطالب بمراجعة استبعادهم من صندوق السكن
- وزيرة الطفولة: رفعنا نمو التعليم ما قبل المدرسي من 9.2% إلى 19.4%
- موريتانيا والسعودية توقعان اتفاقية تنظيم موسم الحج للعام 1447هـ
- وزير التحول الرقمي: الرقمنة أداة لتعزيز الشفافية ومحاربة الفساد
- وزير التحول الرقمي: قطاع المياه يتصدر شكايات منصة “عين”
- سفارة المملكة المتحدة في نواكشوط تحتفي بعيد ميلاد العاهل البريطاني
- الحكومة تؤكد تسوية مستحقات الموظفين وتعزيز المنطقة الحرة بنواذيبو
- الحكومة: منصة "عين" عالجت 97% من نحو 18 ألف شكاية
- ولد بده: الرقمنة تكريس لمحاربة الفساد والشفافية القصوى لا تمكن دونها
- مرسوم لترسيم حدود بُحيرتين في الرياض تفرغ زينة بنواكشوط
- وزير الاقتصاد يؤكد التزام الحكومة بدفع متأخرات الموظفين
- مجلس الوزراء يعتمد خطة لتوحيد جهود التحول الغذائي في البلاد
- الحكومة تُصنّف بحيرتَي تفرغ زينه والرياض مناطقَ ذات نفع عام
- موريتانيا تجدد التزامها بحماية الأطفال في اليوم الدولي للطفل
- بعثة “مينوسكا” تودّع الكتيبة الموريتانية التاسعة بحفل تكريمي في بانغي
- وزير الدفاع يشارك في الدورة الـ19 من معرض دبي للطيران
- الأمم المتحدة توشح الكتيبة الموريتانية التاسعة لحفظ السلام (صور)
- الحكومة تعيد تقييم منصة “عين” بعد سنة من إطلاقها لتعزيز فعالية الخدمات
- اتحاد طلابي موريتاني يندد بعنف النقل الجامعي ويهدد بالتصعيد
- جمعية طلابية لدعم مرضى الكبد تطلق أنشطتها السنوية